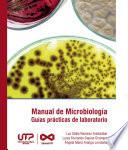
Manual de Microbiología, guías prácticas para laboratorio

Guía Practica de microbiología en agua y alimentos
Autor: Pablo Santiago Baggini
Número de Páginas: 391El agua que se consume así como el alimento que se elabora y se consume, son una responsabilidad de todos los integrantes de la cadena llamada de la Inocuidad o la Seguridad Alimentaria, abarcando desde el productor de la materia prima al consumidor. La propuesta es brindar la herramienta del conocimiento y los fundamentos necesarios para comprender cuales son los escalones en esa empinada escalera de la seguridad en los alimentos: conocer al patógeno y aislarlo, para comprender la morbilidad que causa.